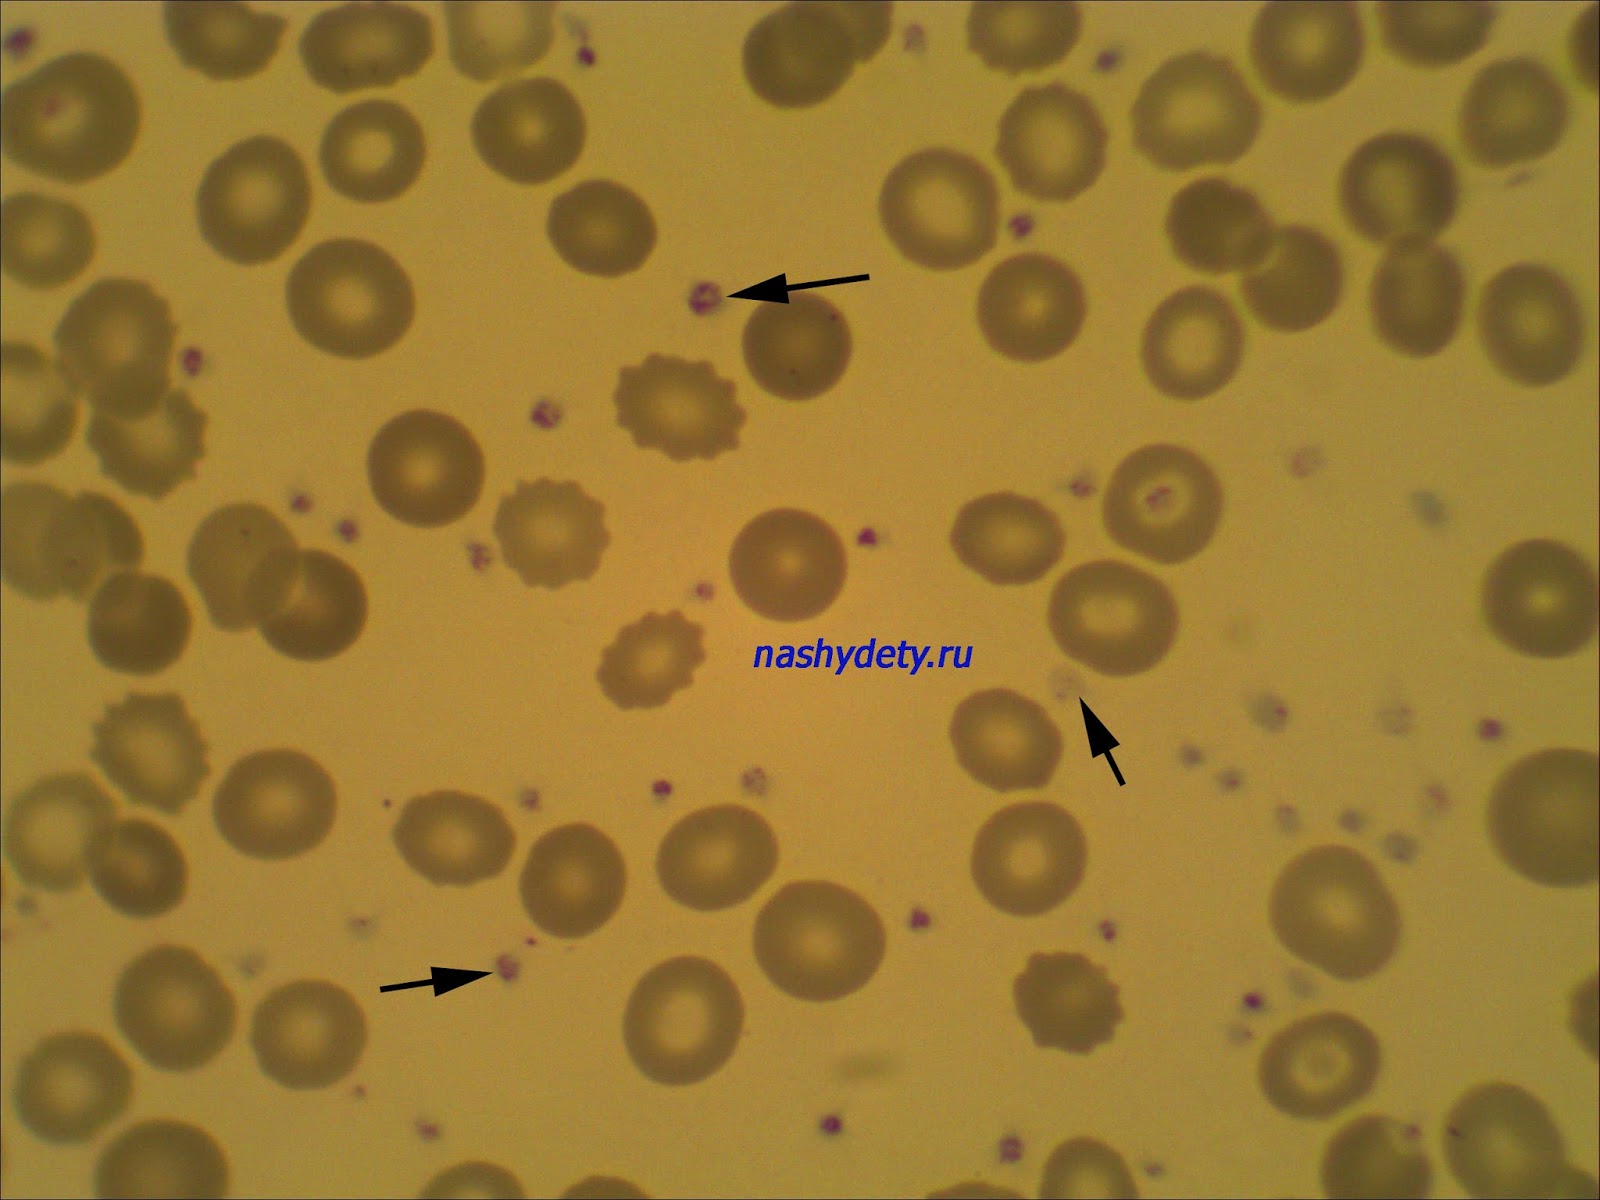

Мазок по фонио
Стул от денола
Скобы rapid 66
Выберите вариант с безличным предложением
Параллельный сдвиговый регистр
Если ты меня разбудишь
До минеральных вод и обратно трек
Розувастатин 10 мг медисорб
Стручковая фасоль на зиму по армянски рецепт
Размеры зубчатой рейки
С днем рождения волонтера своими словами
Я как то отдыхала в объятиях
Алгебра 7 класс номер 54 теляковского
Обстановка на фронтах часов яр
Мазок по фонио 109 фотографий